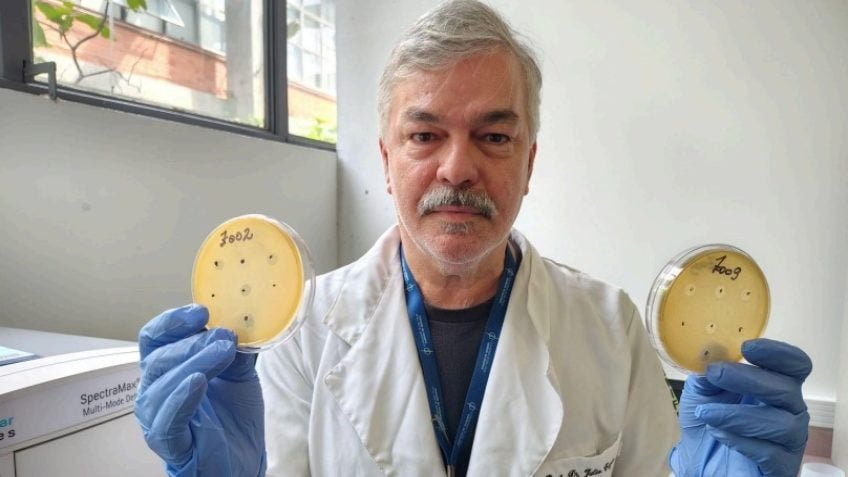

Descoberta foi feita por pesquisadores da Unifesp, USP e Cetesb; vírus podem ajudar no combate a bactérias resistentes a antibióticos
Uma pesquisa conduzida por 3 centros financiados pela Fapesp (Fundação de Amparo à Pesquisa do Estado de São Paulo) resultou na descoberta de 62 novos tipos de fagos –vírus que infectam e matam bactérias.
O trabalho envolveu o Cepid B3 (Centro de Pesquisa em Biologia de Bactérias e Bacteriófagos), o Projeto Aries (Instituto Paulista de Resistência aos Antimicrobianos) e o Centro de Pesquisa em Alimentos, com participação da Cetesb (Companhia Ambiental do Estado de São Paulo) e do Zoológico de São Paulo.
A iniciativa foi liderada por Julio Cezar Franco, professor da Unifesp (Universidade Federal de São Paulo) e pesquisador no CEPID B3. Ele se afastou temporariamente do campus de Diadema da Unifesp para trabalhar no Instituto de Química da USP (Universidade de São Paulo), onde está sediado o Cepid B3. Também colaborou com a professora Aline Maria da Silva (1959–2024).
As primeiras amostras vieram do Aries e da Cetesb, que coleta material em estações de tratamento de esgoto da Grande São Paulo. Também foram usados microrganismos obtidos em hospitais, aeroportos e áreas de compostagem fornecidas pelo Zoológico de São Paulo. O FoRC contribuiu com bactérias associadas à contaminação de alimentos, como as que causam salmonelose.
Franco isolou os fagos das amostras e os testou em placas com bactérias cultivadas em laboratório. Quando um vírus era capaz de matar uma bactéria, surgiam áreas transparentes conhecidas como placas de lise. O processo foi repetido centenas de vezes até a identificação dos 62 novos fagos.
Segundo o pesquisador, os vírus descobertos poderão ser usados para desenvolver estratégias contra bactérias resistentes a antibióticos, problema comum em hospitais, e também para prevenir contaminações em alimentos.
Franco defende a criação de bancos de fagos para aplicação em terapias e no controle biológico de bactérias. O próximo passo, segundo ele, será o sequenciamento dos genomas dos microrganismos para entender como ocorre a infecção e como torná-la mais eficiente.
Ele também pretende ampliar a cooperação entre os centros de pesquisa e incentivar a troca de experiências entre os estudantes das instituições envolvidas.
Com informações da Agência Fapesp